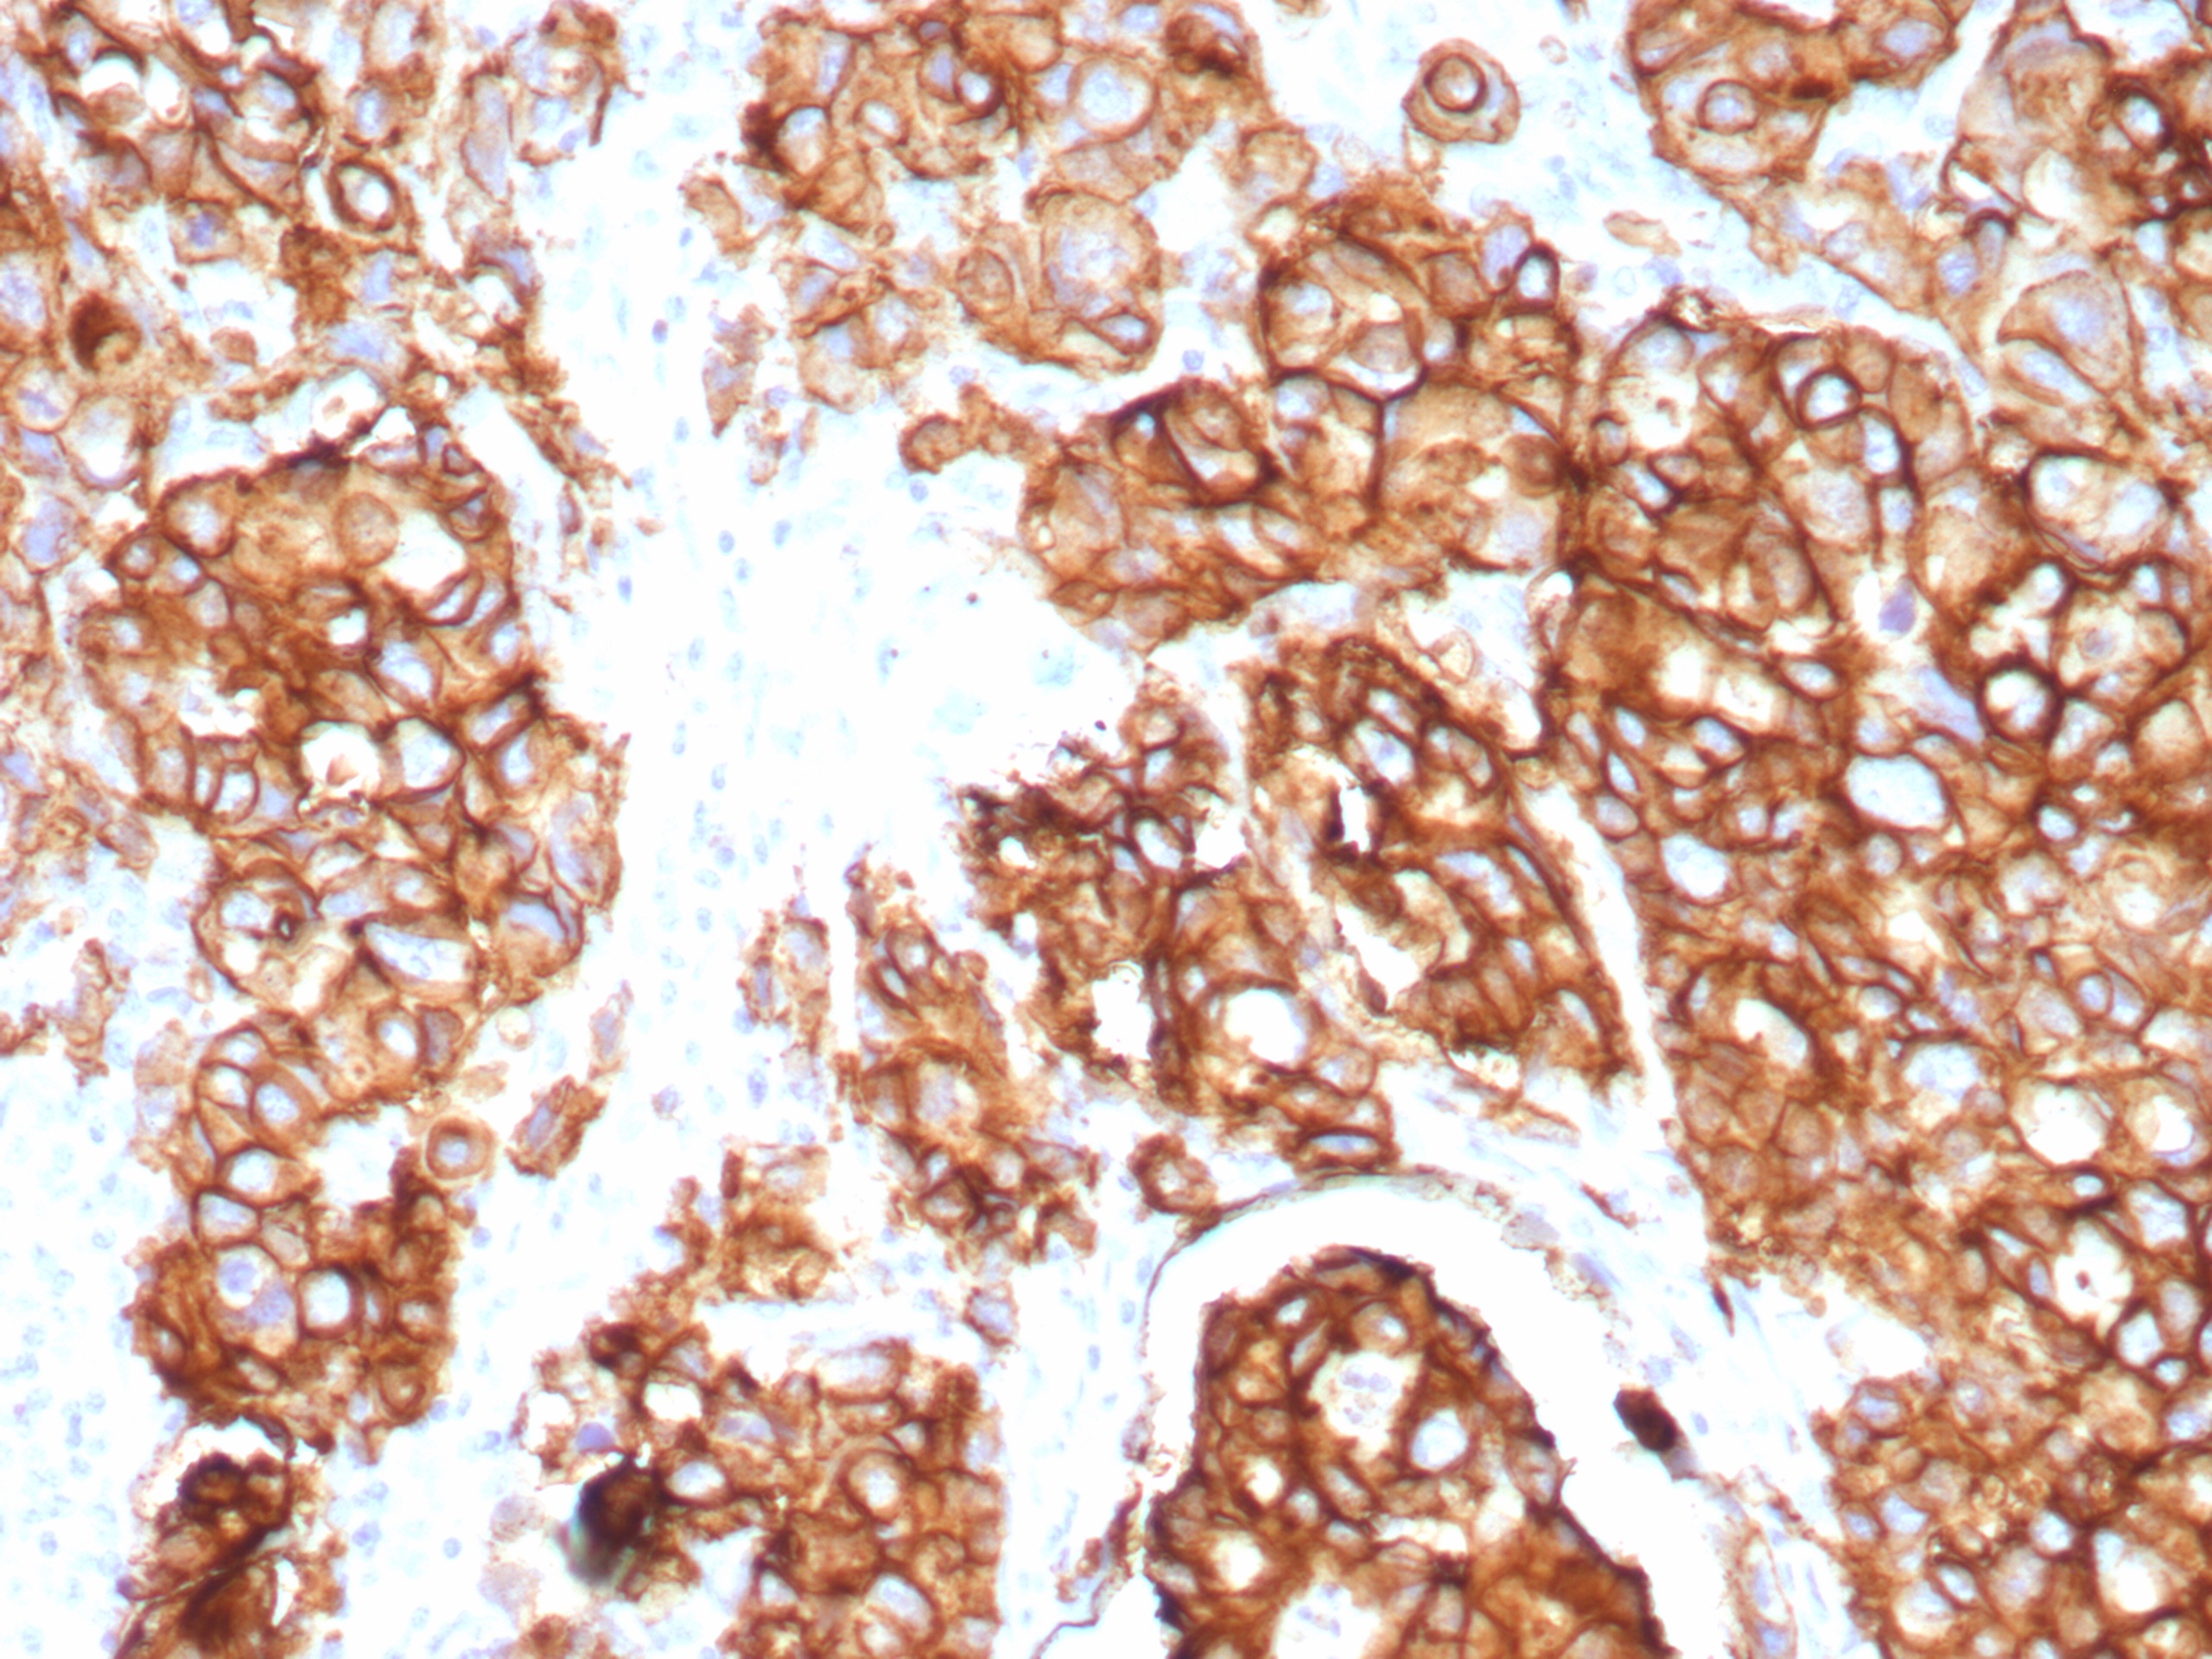

Flow Cytometric Analysis of CAPAN-2 cells using EpCAM Recombinant Rabbit Monoclonal Antibody (EGP40/9774R). Goat anti-Rabbit IgG-CF488 (red); Isotype Control (blue).

SDS-PAGE Analysis of Purified EpCAM Recombinant Rabbit Monoclonal Antibody (EGP40/8774R). Confirmation of Purity and Integrity of Antibody.
Formalin-fixed, paraffin-embedded human colon carcinoma stained with EpCAM Recombinant Rabbit Monoclonal Antibody (EGP40/8774R). Inset: PBS instead of primary antibody; secondary only negative control. HIER: Tris/EDTA, pH9.0, 45min. 2°: HRP-polymer, 30min. DAB, 5min.
Binding epitope of this antibody is located in the first EGF-like repeat domain (EGF1) between amino acids 27-59 of Ep-CAM.EGP40 is a 40-43kDa transmembrane epithelial glycoprotein, also identified as epithelial specific antigen (ESA), or epithelial cellular adhesion molecule (Ep-CAM). It is expressed on baso-lateral cell surface in most simple epithelia and a vast majority of carcinomas with the exception of adult squamous epithelium, hepatocytes and gastric epithelial cells. This antibody has been used to distinguish adenocarcinoma from pleural mesothelioma and hepatocellular carcinoma. This antibody is also useful in distinguishing serous carcinomas of the ovary from mesothelioma.
There are no reviews yet.